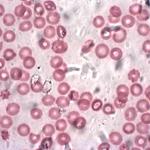

There are four different ABO blood types: A, B, AB, and O. These types depend on the sort of glycoproteins (that is, proteins covered with sugars) that decorate red blood cells (RBCs).
ARDS
Oxygen moves in and out of our bloodstream by the passive process of diffusion – higher amounts moving towards lesser amounts in an attempt to equalize.